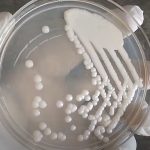
Cryptococcus neoformans: Introduction, Morphology, Pathogenecity, Lab Diagnosis,Treatment and Keynotes

Tag: Classification of Cryptococcus
Cryptococcus neoformans: Introduction, Morphology, Pathogenecity, Lab Diagnosis,Treatment and Keynotes
Introduction of Cryptococcus neoformans Cryptococcus neoformans is a fungus found in...
Introduction of Cryptococcus neoformans Cryptococcus neoformans is a fungus found in...
Cryptococcosis: Introduction, Pathogenesis, Laboratory Diagnosis, Treatment, Prevention and Control
 Introduction of Cryptococcosis Cryptococcosis is an acute, subacute, or chronic...
Introduction of Cryptococcosis Cryptococcosis is an acute, subacute, or chronic...
